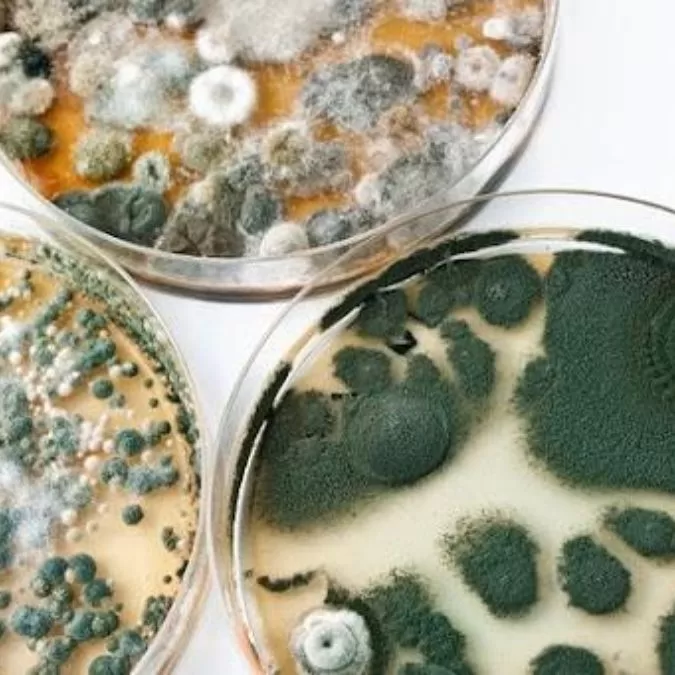
Grzyby adaptogenne Kamil Krzesimowski szkolenie

ROZWÓJ EMOCJONALNY
-
 Podstawy medytacji - praktyczne wskazówki dla początkujących
99,00 zł
Podstawy medytacji - praktyczne wskazówki dla początkujących
99,00 zł
-
 Rozwój intuicji wspierający odnalezienie życiowego celu
149,00 zł
Rozwój intuicji wspierający odnalezienie życiowego celu
149,00 zł
-
 Nie jesteś swoimi myślami.
Nie jesteś swoimi myślami.
10 technik budujących emocjonalną odporność 97,00 zł -
 Jak oswoić zmianę i wykorzystać ją do rozwoju - smakowanie przez doświadczanie
69,00 zł
Jak oswoić zmianę i wykorzystać ją do rozwoju - smakowanie przez doświadczanie
69,00 zł
-
 Siła ciała i umysłu. Praktyczne narzędzia samouzdrawiania intencją.
129,00 zł
Siła ciała i umysłu. Praktyczne narzędzia samouzdrawiania intencją.
129,00 zł
-
 Długi a miłość – jak nie pozwolić, by problemy finansowe zniszczyły Twój związek
69,00 zł
Długi a miłość – jak nie pozwolić, by problemy finansowe zniszczyły Twój związek
69,00 zł
-
 Zrozumieć kobietę – droga do głębokiej, harmonijnej relacji
69,00 zł
Zrozumieć kobietę – droga do głębokiej, harmonijnej relacji
69,00 zł
ZDROWIE FIZYCZNE
-
 Porody i ich wpływ na blokady dzieci w szkole
99,00 zł
Porody i ich wpływ na blokady dzieci w szkole
99,00 zł
-
 Poznaj prawdziwą przyczynę swojego nałogu i odkryj, co naprawdę Cię trzyma
99,00 zł
Poznaj prawdziwą przyczynę swojego nałogu i odkryj, co naprawdę Cię trzyma
99,00 zł
-
 Ukryte przyczyny dziecięcych chorób, czyli jak emocje rodziców wpływają na zdrowie dzieci
99,00 zł
Ukryte przyczyny dziecięcych chorób, czyli jak emocje rodziców wpływają na zdrowie dzieci
99,00 zł
-
 Integralne podejście do odżywiania w chorobie Hashimoto
149,00 zł
Integralne podejście do odżywiania w chorobie Hashimoto
149,00 zł
-
 Kompleksowa diagnostyka i przyczyny choroby Hashimoto
149,00 zł
Kompleksowa diagnostyka i przyczyny choroby Hashimoto
149,00 zł
-
 Naturalne sposoby na pozbycie się pasożytów
89,00 zł
Naturalne sposoby na pozbycie się pasożytów
89,00 zł
-
 Ściągawka sensoryczna dla rodziców (pdf do pobrania)
29,00 zł
Ściągawka sensoryczna dla rodziców (pdf do pobrania)
29,00 zł